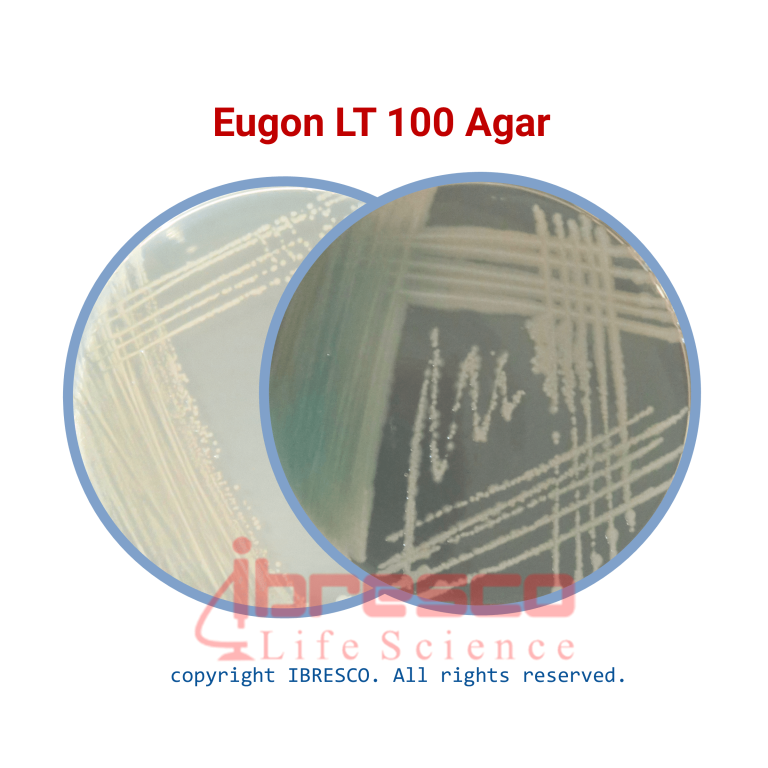
محیط کشت اگون ال تی براث Eugon LT100 ایبرسکو

محیط آگار مورد استفاده برای شناسایی و شمارش باکتری های مزوفیل هوازی در محصولات آرایشی با و بدون نگهداره، مطابق با استاندارد ISO 21149
فرآیند آزمایش
- درصورتی که نمونه مورد آزمایش در آب محلول است، یک رقت 1:10 از آن را با استفاده از یوگن براث تهیه کنید. اگر نمونه در آب حل نمی شود، لازم است که یک امولسیون از آن با استفاده از یک ترکیب مناسب (مانند پلی سربات 80) تهیه شود. امولسیون تهیه شده با رقت مناسب، مثلا 1:10) با یوگن براث ترکیب شود. نمونه هایی که امکان فیلتر کردن آنها وجود ندارد می توانند به روش پورپلیت یا کشت بر روی سطح پلیت، استفاده شوند.
- اگر نمونه مورد نظر، امکان فیلتر کردن را دارد، توصیه می شود از طریق یک فیلتر 0.45 میکرونی، فیلتر شود و با استفاده از حجم مشخصی از آب یا رقیق کننده شسته شود. بلافاصله غشا را بر روی یک پلیت یوگن آگار انتقال دهید.
آماده سازی محیط
- قوطی حاوی پودر محیط کشت اگون ال تی 100 آگار را به خوبی تکان دهید. میزان 45.4 گرم از پودر را وزن کنید و در 1 لیتر آب حل کنید. به خوبی مخلوط کنید.
- مقدار 7 گرم از Part B را به محیط اضافه کنید. به خوبی مخلوط کنید.
- محیط را گرم کنید و به مدت 1 دقیقه بجوشانید تا به صورت کامل حل شود.
- مقدار pH را تنظیم کنید و در دمای 121 درجه سانتی گراد به مدت 15 دقیقه اتوکلاو کنید.
- تا جای ممکن به آرامی محیط را خنک کنید و در دمای 50-45 درجه سانتی گراد در پتری دیش های استریل بریزید.
شرایط نگهداری
پودر محیط داخل قوطی کاملا در بسته و در دمای زیر 30 درجه سانتیگراد و محیط آماده در دمای 8-2 درجه سانتیگراد نگهداری شود. بهترین زمان استفاده تا قبل از تاریخ انقضای درج شده بر روی برچسب محصول است.
کنترل کیفی
- ظاهر محیط دهیدراته: پودی و یکنواخت، بژ
- ظاهر محیط آماده: زرد، کمی کدر (پس از جوشیدن و سرد شدن)
- نتیجه کشت باکتری پس از گرماگذاری در دمای 2 ± 35 درجه سانتی گراد به مدت 24 ساعت
| RecoveryATCCOrganism |
| Good | 25922 | Escherichia coli |
| Good | 27853 | Pseudomonas aeruginosa |
| Good | 25923 | Staphylococcus aureus |
| Good | 14028 | Salmonella thyphi |